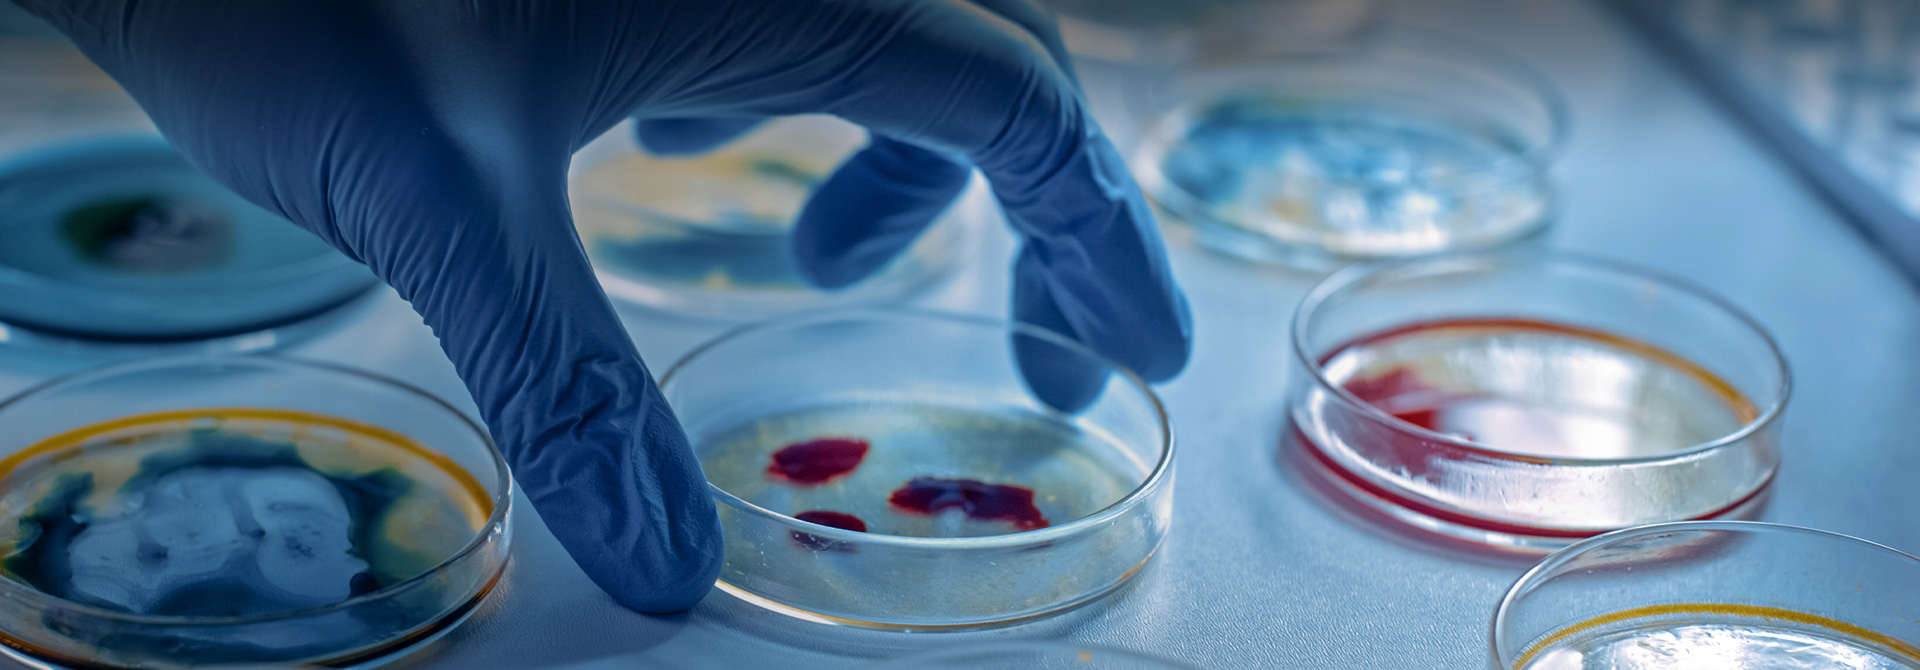

實驗耗材
在科學研究和技術開發(fā)的浪潮中,實驗室耗材作為實驗過程中不可或缺的基礎工具。確保科研耗材的供應鏈不受外部因素影響��,不僅保障著國家科研工作的獨立性和安全性��,也推動著國內科研創(chuàng)新和技術突破���。
公司持續(xù)加大科研投入,在國有實驗室耗材的發(fā)展上����,創(chuàng)建出品質優(yōu)良、價格合理的���,國人自主高端實驗室耗材品牌����。產(chǎn)品線涵蓋生命科學相關試劑耗材���,包括吸頭類、生物樣本庫類��、分子學類等不同類型的耗材產(chǎn)品���,產(chǎn)品廣泛應用于細胞生物學�����、分子生物學�����、蛋白組學��、生物化學等學科,為國內各高等院校�����、研究機構和相關企事業(yè)單位提供配套產(chǎn)品�����。產(chǎn)品以其優(yōu)良的品質受到廣大客戶的一致認可���。